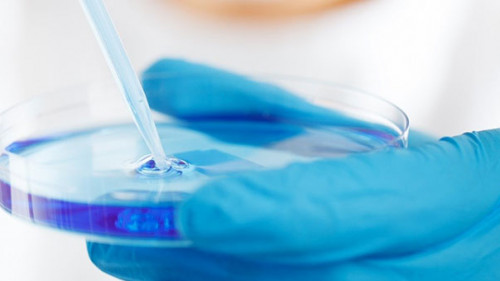
Petrischale-220005-PB-PublicDomainPictures

In den letzten Tagen und Wochen und auch in Zukunft werden wir ausreichend Gelegenheit haben, die Leistungen von Ärzten, Apothekern und Pflegepersonal zu würdigen. Das deutsche Gesundheitssystem wurde und wird anlässlich der Corona-Pandemie in einigen Regionen unserer Republik an und teilweise über die Grenzen seiner Belastbarkeit hinaus gefahren.
Nur allzu gerne nehmen wir eine medizinische 24-Stunden-Rundumversorgung auf hohem Niveau und an sieben Tagen der Woche als Selbstverständlichkeit an: Der schmerzende Weisheitszahn am Wochenende kann auf eine zahnmedizinische Versorgung hoffen und für das dringend benötigte Schmerzmittel darf auch die Nachtglocke des Apothekers betätigt werden. Vor wenigen Tagen wurde der aktuelle Bericht der Rentenkommission 2020 vorgelegt und obwohl die Aussagen in viel Watte verpackt wurden, liegen die harten Fakten auf dem Tisch.
Mit Blick auf die demografischen Parallelverschiebungen wundert es nicht, dass der Generationenvertrag der sozialen Sicherungssysteme immer weniger erfüllt werden kann. Das Instrumentarium des Gesetzgebers beschränkt sich dabei auf eine weitere Absenkung des Renteneingangssatzes, die Anhebung des Beitragssatzes für die gesetzliche Rentenversicherung und die Verlängerung der Lebensarbeitszeit.
Nach der Empfehlung der Rentenkommission sollen ab dem Jahr 2026 der Renteneingangssatz auf bis zu 44 Prozent abgesenkt und der Beitrag zur gesetzlichen Rentenversicherung auf 20 bis 24 Prozent angehoben werden. Eine weitere Verlängerung der Lebensarbeitszeit ist ab dem Jahr 2033 als nicht unwahrscheinlich zu bewerten. Nun könnte an dieser Stelle wieder einmal die Gebetstrommel mit der Aufschrift „Eine Ergänzung der gesetzlichen Altersrente mit einer privaten und/ oder betrieblichen Altersversorgung ist zwingend erforderlich …“ etwas schneller gedreht werden.
Allerdings verhallt die beständig getrommelte Botschaft, dass den Arbeitgebern zunehmend qualifizierte Mitarbeiter fehlen, regelmäßig im Grundrauschen des Alltags. Was betrifft uns der War for Talents in Arztpraxen und Kliniken, wir sind ja schließlich alle mit uns selbst beschäftigt. Aber spinnen wir den Faden einmal weiter, der unter dem Horizont der Corona-Pandemie auf einmal eine ganz andere Wertigkeit erhält. Was würden wir tun, wenn im Fall einer Erkrankung kein Arzt für uns Zeit hätte, keine Krankenschwester und auch kein Krankenpfleger wegen akuter Personalnot auf der Station zur Verfügung stehen würde?
Das SARS-CoV-2-Virus führt uns gegenwärtig weltweit mit drastischen Bildern vor Augen, was passiert, wenn nicht ausreichend Personalkapazitäten in der medizinischen und pflegerischen Versorgung zur Verfügung stehen! Genau an dieser Stelle kann jeder engagierte Versicherungsmakler einen wichtigen Beitrag leisten und die Arbeitgeber im Heilwesen mit einer qualifizierten und engagierten Beratung bei der Mitarbeitergewinnung und -bindung unterstützen. Und die KlinikRente liefert für den Beratungsprozess die geeigneten Instrumente.
Ob betriebliche Altersversorgung oder individuelle Absicherung der Arbeitskraft, die Tarifwelt bietet hochwertige Vorsorgelösungen für den Aufbau einer zusätzlichen Altersversorgung und die Absicherung der persönlichen Arbeitskraft. Neben dem Klassiker Berufsunfähigkeitsversicherung findet sich auch die Vorsorgealternative Grundfähigkeitenversicherung im Tarifportfolio der KlinikRente. Konsortialführer für die KlinikRente Arbeitskraftabsicherung ist die Swiss Life AG.
Weit gefasst – das Leistungsportfolio
Sowohl für die Berufsunfähigkeits- als auch für die Grundfähigkeitenversicherung ist die Swiss Life AG ein Garant für hochwertige Premiumtarife und eine äußerst qualifizierte Leistungsfallbearbeitung im Versicherungsfall. Die Tariflösungen der KlinikRente sichern den zugangsberechtigten Versicherungsnehmern allerdings nicht nur Premiumtarife für die Einkommensabsicherung, sondern auch rabattierte Beiträge und im Fall der Grundfähigkeitenversicherung KlinikRente. Vitalschutz einen zusätzlichen Leistungsauslöser für die versicherte Grundfähigkeit Gebrauch einer Hand.
Die Zugangsvoraussetzungen zum Tarifwerk der KlinikRente und damit der Kreis der potenziellen Neukunden wurde von den Konsortialgesellschaften weit gefasst. Neben niedergelassenen und Krankenhausärzten, dem klinischen Pflege- und dem Personal in der Verwaltung haben auch Apotheker sowie Zahnärzte und deren Arbeitnehmer, aber auch Studenten der (Zahn-)Medizin und die Familienangehörigen der vorgenannte Berufsgruppen Zugang zu den Tarifen der KlinikRente. Mit der Überarbeitung ihrer Berufsunfähigkeitsversicherung hat die Swiss Life AG im März 2020 nicht nur wichtige tarifliche Verbesserungen umgesetzt und den Antragsprozess weiter verschlankt, sondern auch für viele Berufe die Beiträge neu kalkuliert.
So wurden beispielsweise die Beiträge für Physiotherapeuten, die nach den Tarifen der KlinikRente versichert werden, um bis zu 28 Prozent gesenkt. Auch die Annahmerichtlinien wurden verbessert und die maximal zulässigen Berufsunfähigkeitsrenten für Schüler und Studenten nochmals erhöht. Vor allem Ärzte, Apotheker und Zahnärzte mit einem hohen Einkommen sollten auf eine rechtzeitige Absicherung des Berufsunfähigkeitsrisikos ihrer Kinder angesprochen und damit deren Gesundheitszustand konserviert werden. Der Versicherungsschutz kann dann mit umfangreichen Nachversicherungsoptionen ohne erneute Gesundheitsprüfung weiter ausgebaut werden.
Wertschätzung aller im Gesundheitswesen
Wir sollten alle mit Blick auf die aktuelle Situation die Qualität der medizinischen Versorgung in Deutschland überdenken. Wie die dramatische, um nicht zu sagen apokalyptische Situation in einigen unserer Nachbarländer zeigt, ist ein leistungsfähiges Gesundheitssystem mit ausreichend technischer Einrichtung keine Selbstverständlichkeit.
Wir brauchen gleichermaßen engagierte wie gut ausgebildete Ärzte. Motivierte Krankenschwestern und -pfleger und auch Altenpfleger/-innen sind in unserer überalternden Gesellschaft zwingend erforderlich.
Es ist also das Gebot der Stunde, dass wir nicht nur unseren Leistungsträgern im Gesundwesen unseren Respekt zollen, sondern auch die Arbeitgeber über die verfügbaren Vorsorgeinstrumente zur Wertschätzung der bestehenden Belegschaft sowie zur Mitarbeitergewinnung vorstellen.
Die KlinikRente bietet Arbeitgebern betriebliche Versorgungslösungen, aber auch die Möglichkeit einer einzel- wie kollektivvertraglichen Absicherung der Arbeitskraft und des Risikos einer Pflegebedürftigkeit. Der Zugang zur KR.bAV ist möglich ab einer Beschäftigtenzahl von zehn Personen. Somit können sich große Kranken- und Pflegeeinrichtungen absichern, genauso wie Arztpraxen, Apotheken oder Zahntechnikerlabore.
Themen:
LESEN SIE AUCH
Swiss Life erneuert Berufsunfähigkeits- und Grundfähigkeitsversicherung
BdV soll fehlerhafte Studie zur Kombination von Arbeitskraft- und Alterssicherung zurückzuziehen
Swiss Life verbessert BU-Angebot für über 800 Berufe
VEMA-Makler: die Favoriten in der Arbeitskraftabsicherung
Unsere Themen im Überblick
Themenwelt
Wirtschaft
Management
Recht
Finanzen
Assekuranz
Macht Platz – Für echte Solidarität nicht nur in der Versicherungsbranche
Kunstraub im Louvre: „Ein Stück der Geschichte Frankreichs ist ausgelöscht“
Lebensversicherung: Zwischen Stabilisierung und Spreizung
VEVK ruft das „Jahr der 1. Tugend“ aus
Die neue Ausgabe kostenlos im Kiosk
Werfen Sie einen Blick in die aktuelle Ausgabe und überzeugen Sie sich selbst vom ExpertenReport. Spannende Titelstories, fundierte Analysen und hochwertige Gestaltung – unser Magazin gibt es auch digital im Kiosk.